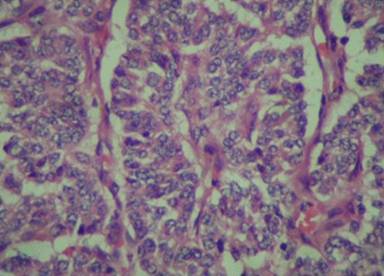
08_fig02.jpg

CASE REPORT
JOP. J Pancreas (Online) 2010 Sep 6; 11(5):444-445.
Splenic Mass and Isolated Gastric Varices: A Rare Presentation of a Neuroendocrine Tumor of the Pancreas
Sneha A Shah1, Anjali D Amarapurkar1, Sudesh R Prabhu2, Vineet Kumar2, Gautam K Gangurde2, Rajeev M Joshi2
Departments of 1Pathology and 2Surgery, TN Medical College and BYL Nair Ch Hospital. Mumbai, India
ABSTRACT
Context Splenic involvement in neuroendocrine pancreatic tumors is well known but rarely presents as a primary splenic mass. Case report A rare case of a neuroendocrine tumor involving the tail of the pancreas, splenic hilum and splenic flexure of the colon, forming a conglomerate mass and presenting as isolated gastric varices is described. A 75-year-old male presented with hematemesis and melena. Esophagogastroduodenoscopy revealed isolated gastric varices. A CT scan revealed a mass predominantly involving the spleen and a small part of the pancreas. Conclusion A splenic mass with isolated gastric varices should be kept in mind as one of the presentations of a pancreatic neuroendocrine tumor.
INTRODUCTION
Splenic involvement in neuroendocrine pancreatic tumors is well known but rarely presents as a primary splenic mass. The distal portion of the pancreatic tail extends along the course of the splenic artery and vein, and enters into the hilum of the spleen contained within the splenorenal ligament. As a consequence of these anatomical relationships, the spleen and its vasculature may be involved in disorders affecting the pancreas.
CASE REPORT
A-75-year old male presented as an outpatient in our department with a history of 2-3 episodes of hematemesis and small amounts of melena. His vital parameters were stable. He did not require any transfusion or hospitalization or had he had any past history of major illness. The patient had no history of alcoholism. Esophagogastroduodenoscopy revealed isolated gastric varices in the fundus. A heterogeneous mass of 4.5x4.3 cm in the spleen with marked vascularity was revealed at ultrasonography. Hence, a CT scan was advised. The CT scan demonstrated a 4.5x4.3 cm heterogeneously enhancing mass mainly in the splenic hilum and the tail of the pancreas with marked vascularity. The mass showed focal calcification with involvement of the splenic vein (Figure 1). There was no evidence of distant metastasis and no evidence of abdominal lymphadenopathy. The pre-operative diagnosis was primary splenic neoplasm (angiosarcoma) or a pancreatic tail tumor.

|
Figure1. Postcontrast axial CT scan in the arterial phase showing a solitary large contrast-enhanced lesion in the spleen. |
|
|
The patient underwent an exploratory laparotomy. Intraoperatively, a 4.5x4.3 cm tumor seen mainly at the splenic hilum invading the splenic parenchyma, extending to the tail of the pancreas and encasing the splenic vein. The splenic flexure of the colon was adherent to the spleen which showed infiltration by the tumor. A distal pancreatectomy and splenectomy were carried out along with resection and anastomosis of the splenic flexure of the colon. There were no enlarged lymph nodes. The postoperative course was uneventful.
On macroscopic examination, the tumor measured 4x4x3 cm and diffusely infiltrated the splenic parenchyma at the hilum. The tail of the pancreas revealed a 0.5x0.5 cm white firm nodule. A small segment of the colon, which was adherent to the mass, showed a nodule on the serosa, measuring 3x2x0.5 cm. The mucosa was unremarkable. The tumor was firm, yellowish-white and had infiltrating borders. There were no areas of necrosis or hemorrhage. There were no lymph nodes in the specimens sent.
Microscopic examination of the splenic tumor showed uniform cells arranged in a trabecular pattern with stippled chromatin and scant cytoplasm suggestive of a neuroendocrine tumor. Pancreatic and colonic nodules also showed similar morphology (Figure 2). Immunohistochemistry was carried out which revealed diffuse positivity of synaptophysin. Chromogranin A and cytokeratin also showed positivity; Ki67 was 5%.
The final report was well-differentiated neuroendocrine carcinoma of the pancreas (according to the WHO classification [1]) with splenic involvement and no lymph node metastasis, stage T4 (according to TNM classification [2]).
|
Figure 2. Microscopy section from the spleen showing the neuroendocrine tumor (H&E 400x). |
|
|
DISCUSSION
Neuroendocrine tumors of the gastroenteropancreatic system are rare and originate from a diffuse endocrine system located in the gastrointestinal tract and the pancreas with extremely varying presentations [2]. Gastroenteropancreatic neuroendocrine tumors comprise 2% of the tumors of the gastrointestinal tract and 1-2% of all pancreatic tumors [3]. The clinical features of gastroenteropancreatic neuroendocrine tumors are very heterogeneous. They may be asymptomatic for years, or present with abdominal pain, nausea, vomiting or cholestasis [2]. Approximately 50% of pancreatic neuroendocrine tumors are known to present with metastasis, as was seen in our case. Invasion of the spleen represented metastasis in this case. In addition to this, as is seen in the literature, pancreatic neuroendocrine tumors can also present with isolated gastric varices [4]. Due to the vagueness of the symptoms, diagnosis can be delayed. In general, malignant metastasizing pancreatic endocrine tumors are slow-growing neoplasms. Survival from the time of diagnosis usually ranges from 2 to 10 years [3].
Usually, neuroendocrine tumors involving the spleen can represent metastases from adjoining organs such as the pancreas. Imaging has an important role in localizing the primary tumor and identifying metastatic sites. Investigations include CT and MRI, and newer modalities, including endosonography and somatostatin receptor scintigraphy, are highly sensitive for detecting carcinoids presenting 80-100% sensitivity [5]. Many neuroendocrine tumors, including pancreatic neoplasms, express somatostatin receptors which can be demonstrated by autoradiography [6], even in percutaneous biopsy samples, by scintigraphic imaging or by immunohistochemistry.
Gastric varices in the absence of esophageal varices are called as isolated gastric varices. They are usually secondary and develop when esophageal varices are obliterated. The most common cause is liver cirrhosis in patients with portal hypertension. If there is no portal hypertension, segmental portal hypertension can cause isolated gastric varices via obstruction of the splenic vein, as in our case, or splenic vein obstruction by tumor mass [7]. Madsen et al. studied 209 patients with isolated splenic vein obstruction of whom 63% had chronic pancreatitis and 18% had pancreatic neoplasm [8]. Hence, a splenic mass with isolated gastric varices should be kept in mind as one of the presentations of pancreatic neuroendocrine tumors.
Received April 9th, 2010 - Accepted April 28th, 2010
Key words Chromogranin A; Esophageal and Gastric Varices; Hypertension, Portal; Neuroendocrine Tumors; Splenic Neoplasms
Conflict of interest The authors have no potential conflict of interest
Correspondence
Rajeev
M Joshi
Department of Surgery
T.N. Medical College and B.Y.L.
Nair Ch. Hospital
Dr A.L.Nair road
400008 Mumbai
India
Phone: +91-982.054.0565
Fax: +91-22.2307.5243
E-mail: joshirm@vsnl.net
References
1. Heitz PU, Komminoph P, Perren A, Klimstra DS, Dayal Y, Bordi C, et al. Tumors of endocrine pancreas. In: Ronald A, De Lellis, Ricardo V. Lioyd, Philipp U. Heitz, Pharis Eng, eds. World Health Organisation-Classification of Tumor (Vol. 8). Pathology and Genetics. Tumors of Endocrine Organ. IARC Lyon France, 2004: 175-208. [ISBN 9789283224167]
2. Massironi S, Sciola V, Peracchi M, Ciafardini C, Spampatti MP, Conte D. Neuroendocrine tumors of the gastro-entero-pancreatic system. World J Gastroenterol 2008; 14:5377-84. [PMID 18803349]
3. Kloppel G, Heitz PU. Tumors of the endocrine pancreas. In: Fletcher CD, ed. Diagnostic Histopathology of Tumors. 3rd edition. Philadelphia USA, 2007, Elsevier Churchill Livingstone, 1123-37.
4. Wong SW, Lee KF, Lai PB. Pancreatic neuroendocrine tumor presented as isolated gastric varices. Can J Surg 2007; 50:143-4. [PMID 16447473]
5. Hanson MW. Scintigraphic evaluation of neuroendocrine tumors: indium-111 octreoscan. Appl Radiol 2001; 30:11-17.
6. Reubi JC, Hacki WH, Lamberts SW. Hormone producing gastrointestinal tumors contain a high density of somatostatin receptors. J Clin Endocrinol Metab 1987; 65:1127-34. [PMID 2824549]
7. Sarin SK, Jain AK, Lamba GS, Gupta R, Chowdhary A. Isolated gastric varices : prevalence, clinical revelance and natural history. Dig Surg 2003; 20:42-7. [PMID 12637804]
8. Madsen MS, Petersen TH, Sommer H. Segmental portal hypertension. Ann Surg 1986; 204:72-7. [PMID 3729585]